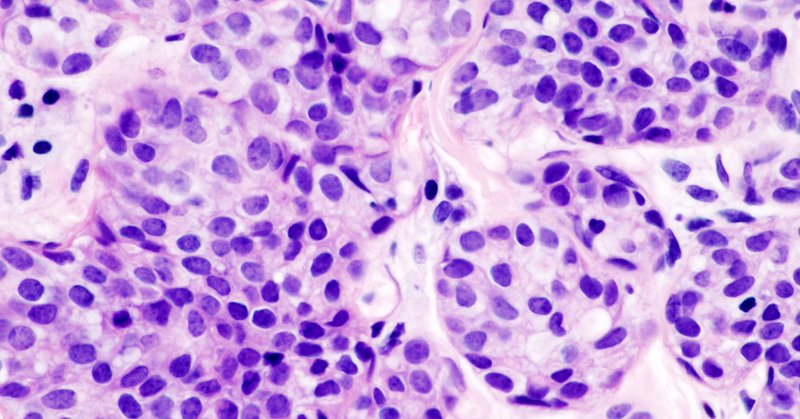
Tweet card summary image

Rashi Kalra
@RashiKalra49
Followers
20
Following
56
Media
0
Statuses
12
Cancer Researcher
Birmingham, Alabama
Joined September 2021
What a better way to close 2022 than to see the top five most viewed posts of the year! @DrRosengart @shyamkavuri @RashiKalra49 @ThINKSavatic @DamianYoung29 @RosenbergLabBCM @FengYang_MedBio @BCMGradSchool @BCM_Alumni @BCMCancerCenter
https://t.co/lznPrN2zOX via @bcmhouston
blogs.bcm.edu
The top five most popular posts, from heart disease research to recognition of the achievements of outstanding faculty members.
0
5
18
Drs. @shyamkavuri, @RashiKalra49, @naborala et al studied #HER2 #metastatic #breastcancer resistance to #therapy and found a potential new drug to treat it @BCMDeptMedicine @BCMCancerCenter @AACR #CancerResearch @CPRITTexas @MeenakshiAnurag
https://t.co/od8OxGFJ09
@bcmhouston
blogs.bcm.edu
A phase II clinical trial is on its way to assess the value of poziotinib in the treatment of this devastating condition.
2
8
13